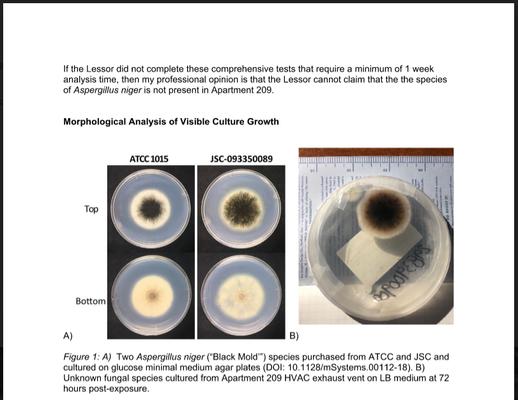
Report of Mold

Arlington Cemetery
320 E 4th St
Arlington, TX 76010
Arlington Cemetery is a peaceful and well-maintained final resting place for individuals in the Arlington, TX area.
Offering a serene and respectful environment, the cemetery provides burial services for those looking for a dignified place of remembrance.
Generated from their business information
Also at this address
See a problem?
You might also like
Partial Data by Foursquare.